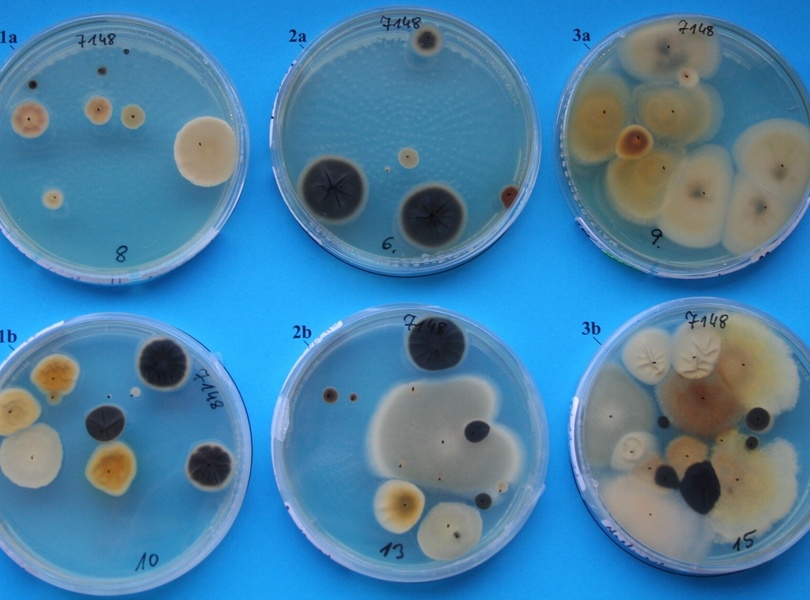

Tipp: Autowäsche zum Frühling - Runter mit dem Restsalz
Der Winter ist vorbei – spätestens jetzt sollte das Auto in die Waschanlage. Der ADAC empfiehlt zunächst eine

mid Groß-Gerau - Gesunde Atemluft im Auto. Tunap
mid Groß-Gerau - Entnommene Kfz-Luftproben auf Nährboden. Tunap

mid Groß-Gerau - Verdampfer und Pollenfilterbox vor und nach der Reinigung. Tunap
Was bei der Pflege rund um das Auto oft vergessen wird, ist die Wartung und die professionelle Reinigung der Klimaanlage. Der Verein Deutscher Ingenieure (VDI) und der Zentralverband Deutsches Kraftfahrzeuggewerbe (ZDK) haben daher den Hygiene-Standard für Klimaanlagen im Auto neu definiert.
Der Winter ist vorbei – spätestens jetzt sollte das Auto in die Waschanlage. Der ADAC empfiehlt zunächst eine
Die Sonne zeigt sich länger, die Temperaturen steigen - und mit den kommenden langen Wochenenden wächst bei
Autofahrer sollten in ländlichen Gegenden vor allem morgens wieder besonders vorsichtig sein: Durch die Umstellung
Transporter und Nutzfahrzeuge sind im täglichen Einsatz besonderen Belastungen ausgesetzt. Dabei gehören beschädigte
In der Bauwirtschaft sind Lastkraftwagen und Zugmaschinen längst nicht mehr nur reine Transportfahrzeuge. Moderne
Wer in Hamburg unterwegs ist, kennt die Herausforderungen des Stadtverkehrs: Staus, kurze Strecken und einmal
Das Flugzeug ist in den Augen der Deutschen das sicherste Verkehrsmittel. Am Ende des Rankings, das die HUK-Coburg
Mit steigendem Alter des Fahrers wird der Spritverbrauch des Autos wichtiger. Während für nur 29 Prozent der
